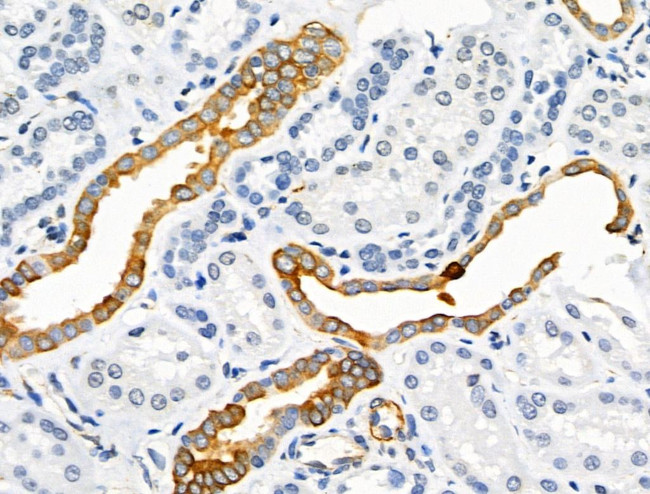
Phospho-Synapsin 1 (Ser605) Antibody in Immunohistochemistry (Paraffin) (IHC (P))

Search
Invitrogen
Phospho-Synapsin 1 (Ser605) Polyclonal Antibody
{{$productOrderCtrl.translations['antibody.pdp.commerceCard.promotion.promotions']}}
{{$productOrderCtrl.translations['antibody.pdp.commerceCard.promotion.viewpromo']}}
{{$productOrderCtrl.translations['antibody.pdp.commerceCard.promotion.promocode']}}: {{promo.promoCode}} {{promo.promoTitle}} {{promo.promoDescription}}. {{$productOrderCtrl.translations['antibody.pdp.commerceCard.promotion.learnmore']}}
图: 1 / 4
Phospho-Synapsin 1 (Ser605) Antibody (PA5-104662) in IHC (P)




Please note: We are reviewing Western blot images included in the antibody testing data in our catalog, including those provided by third parties. Unless expressly labeled or annotated as “raw-unedited”, Western blot images included in the antibody testing data in our catalog may have been edited, optimized or otherwise adjusted for presentation.
产品信息
PA5-104662
种属反应
宿主/亚型
分类
类型
抗原
偶联物
形式
浓度
规格
纯化类型
保存液
内含物
保存条件
运输条件
RRID
产品详细信息
Antibody detects endogenous levels of Synapsin I only when phosphorylated at Ser605.
靶标信息
SYN1 (synapsin 1) is a member of the synapsin gene family. Synapsins encode neuronal phosphoproteins that associate with the cytoplasmic surface of synaptic vesicles. Family members are characterized by common protein domains and are implicated in synaptogenesis and the modulation of neurotransmitter release, suggesting a potential role in several neuropsychiatric diseases. Synapsin 1 plays a role in regulation of axonogenesis and synaptogenesis. It serves as a substrate for several different protein kinases and phosphorylation may function in the regulation of this protein in the nerve terminal. Mutations in this gene may be associated with X-linked disorders with primary neuronal degeneration such as Rett syndrome. Alternatively spliced transcript variants encoding different isoforms have been identified.
仅用于科研。不用于诊断过程。未经明确授权不得转售。
篇参考文献 (0)
生物信息学
蛋白别名: Brain protein 4.1; synapsin 1; Synapsin I; Synapsin-1; truncated synapsin 1-S
基因别名: Syn-1; SYN1; Syn1-S
UniProt ID: (Rat) P09951, (Mouse) O88935
Entrez Gene ID: (Rat) 24949, (Mouse) 20964